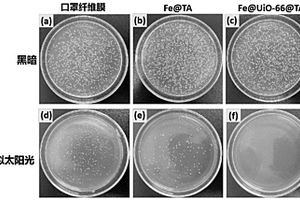

全部

 950
950
 0
0
本发明公开了一种碳纤维用界面增强型碳纳米管上浆剂及其制备方法,由以下重量份的组分组成:水60-80份,环氧树脂20-40份,乳化剂0.01-6份,改性碳纳米管0.002-1.2份,其中,所述改性碳纳米管为表面接枝环氧官能团的碳纳米管。将碳纳米管混合于强酸溶液中,反应得到表面含有羧基官能团的碳纳米管,将得到的表面含有羧基官能团的碳纳米管与溶剂混合后得到混合液A,将环氧树脂与溶剂混合后得到混合液B,将混合液A和混合液B混合后,加热反应后,得到改性碳纳米管。本发明的上浆剂中含有碳纳米管,碳纳米管长径比高,提高制备成型的复合材料材的力学性能,采用碳纳米管外层包覆环氧树脂的核壳结构,能够保证碳纳米管有效地附着在碳纤维表面。

 787
787
 0
0
本发明公开了一种纤维织物厚度方向渗透率测试装置,包括上模、下模、模腔厚度支架;本发明还公开了一种纤维织物厚度方向渗透率的测试方法,包括如下步骤:注射前的准备步骤;注射的步骤;测量试验数据,并计算渗透率的步骤。本发明重点分析预制件的多层次结构、多类型单胞及其排列组合方式对预制件渗透率空间分布的影响,建立渗透率及其分布与结构相关性的数学模型,揭示复合材料浸润缺陷的形成机理与规律,发展浸润缺陷的形成判据与控制方法,从而促进复合材料在我国航空航天、汽车、建筑、风电等领域的应用和推广。

本发明涉及陶瓷基复合材料及其制备工艺,尤其是一种用于制备原位生长碳化钽晶须增韧氧化铝基陶瓷刀具材料及其制备工艺。材料成分质量比为%:Ta2O5?25.4%-38.0%;C?4.8%-7.2%;NaCl?1.7%-2.5%;Ni?1.7%-2.5%;Al2O3?49.8%-66.4%。制备工艺为:将按比例配制的原材料装入缸式球磨机中,用氧化铝球湿磨24h;混合料在100-120℃下真空干燥后用100目过筛;将粉料装入端部有盖、下方封闭、中间有多孔的石墨容器中,在高温炉内进行原位生长晶须培养;在升温速率为100℃/min、氩气气氛保护、温度为1350-1500℃下保温50-80min并以20℃/min的速率冷却至室温合成复相粉末;去除残留杂质,在真空氛围和1600-1800℃温度下加压至32MPa保温15-45min烧结成型。本发明用两步工艺制备的陶瓷刀具材料,晶须分散均匀、工艺简单、材料的综合力学性能优良,成本低廉、环保、安全。

一种用于改善润滑油性能的铜铝复合纳米颗粒的制备方法及使用该复合纳米颗粒的润滑油,包括如下步骤:得到无机铝的醇溶液作为溶液A;得到有机铜的醇溶液作为溶液B;将溶液A和溶液B混合后加入油酸得到混合溶液;将无机碱的醇溶液加入到混合溶液当中得到反应液;将反应液进行充分搅拌后进行加热加压反应,过滤清洗得到复合纳米材料。本文采用非水解溶胶一步法制备了CuO/Al2O3纳米复合材料并对其进行了改性。将改性CuO/Al2O3纳米复合材料以0.1wt%的优化浓度加入润滑油中,摩擦副的平均COF降低了38.6%,WSD降低了39.1%。

 1113
1113
 0
0
本发明涉及一种含氧化石墨烯量子点原位还原银纳米颗粒的反渗透复合膜,本发明先将银纳米颗粒原位还原到氧化石墨烯量子点上,得到一种抗菌复合材料,再把该抗菌材料加入反渗透膜的聚酰胺层中,得到既具高水通量、高截盐,又具有高抗污染性,高抗菌性的反渗透复合膜,具有良好的稳定性,在水处理、膜分离领域具有广泛的应用前景,氧化石墨烯量子点含有众多含氧官能团,为银纳米粒子的生长提供大量成核位点,有效防止了银纳米颗粒的聚集,提高了杀菌复合材料的比表面积,大大提高了杀菌效率。

本发明公开了一种CeO2和Co3O4杂化Ce‑MOF/Co‑MOF复合催化剂的制备方法以及基于该催化剂用于电催化室温氮气还原的应用,属于纳米材料技术、催化技术等领域。其主要步骤是先用硝酸铈溶液和间苯三甲酸配体溶液制备Ce‑MOF晶体;将硝酸钴溶液与Ce‑MOF晶体溶液混合,并加入碳酸钠溶液,制得Ce‑MOF/Co‑MOF复合材料,将该复合材料置于管式炉中,空气气氛下250 ℃氧化‑分解2 h,得到CeO2和Co3O4杂化Ce‑MOF/Co‑MOF复合催化剂;将该催化剂用于电催化室温氮气还原,该催化剂制备工艺简单,耗时短,成本低,有很好的工业前景。

 763
763
 0
0
本发明提供一种脱氢酶电极及其制备方法。该电极包括基底电极、涂敷于所述基底电极上的电子传导层和涂敷于所述电子传导层上的脱氢酶层,所述电子传导层为仿生纳米复合材料;所述脱氢酶层为仿生纳米复合材料/脱氢酶复合物。其制备方法包括:a、将碳纳米材料和生物大分子超声分散的悬浊液滴涂于基底电极上形成电子传导层;b、将脱氢酶加入上述悬浊液超声处理得到固定化脱氢酶体系滴涂于上述电子传导层上形成脱氢酶层。该脱氢酶电极能在低电位下实现辅酶的电化学再生,操作简单、检测灵敏度高、电极稳定性重现性好、酶活损失小。

 884
884
 0
0
陨石净水器属于健康饮水设备领域。陨石净水器是将陨石破碎成适当大小的颗粒,与铝镁合金颗粒一起混合到微电解高能复合材料中,再将这种含有陨石颗粒和铝镁合金颗粒的高能复合材料装入陨石微电解能量罐中,最后组装成陨石净水器;进水管接在自来水管上,自来水依次进入PP棉过滤器、活性炭过滤器、超滤膜过滤器、微电解陨石能量罐、后置活性炭过滤器,最后由出水管流出。本项目的有益效果是,利用陨石作为净水器的高能量源,从而大大提升了健康饮水设备的效能和出水品质,为人类健康饮水事业增添了正能量,大大提升了用户的生活质量和幸福指数。

本发明提供了一种以生物质基碳为结构支架的电催化剂及其制备方法与应用,该电催化剂的制备方法包括步骤:取固态动物血液,经去离子水浸泡、离心洗涤后,将所得血液固体于金属盐溶液中浸泡,之后经干燥得到含金属离子的血液固体;将得到的含金属离子的血液固体在惰性气体中热解,降至室温后研磨,再经化学后处理,得到金属化合物/C三维复合材料,即以生物质基碳为结构支架的电催化剂。本发明首次采用动物血液作为碳源,提供了一种低成本、易于实现的碳支架设计思路,得到的金属化合物/C复合材料表现出较为优异的电催化析氧性能。

本发明涉及一种含偕胺肟基的三维环糊精/石墨烯气凝胶复合吸附材料及其制备方法与应用,本发明选用偕胺肟化的二氨基马来腈与氧化石墨烯的含氧官能团及环糊精的含氧官能团结合,一方面引入了偕胺肟基团,大大增强了复合材料对六价铀的选择吸附能力,另一方面偕胺肟化的二氨基马来腈富含氨基,可以与氧化石墨烯片层上的含氧基团以及羧甲基‑β‑环糊精上的含氧基团反应,从而使偕胺肟基团交联到石墨烯气凝胶上,增加气凝胶的交联度,有利于气凝胶的形成,同时使复合材料的比表面积得到大幅度提升,赋予了材料较强的吸附能力,用于富集六价铀富集率高、吸附时间短。

 1157
1157
 0
0
本发明属于氧化剂制备技术领域,公开了一种用于氧析出和氧还原的双功能催化剂及其制备方法,取泡沫镍,浸入HCl溶液中,取出用去离子水清洗,然后在烘箱中干燥;将泡沫镍放入含有CoCl2·6H2O和NiCl2·6H2O的溶液中用循环伏安法在泡沫镍表面沉积氢氧化镍钴复合材料;将经过电沉积之后得到的泡沫镍取出,洗涤后干燥;将泡沫镍与三聚氰胺混合物和硫脲分别置于双区温度控制管式炉的下风口部和上风口部,进行加热。本发明的催化剂在OER中的起始电势为1.52V(vs.RHE),在ORR中,与20%商业Pt/C作对比,起始电位为0.95V(vs.RHE),具有更好的甲醇耐受性和稳定性。

 1098
1098
 0
0
本发明属于染料污染与环境修复的技术领域,涉及一种氧化石墨烯秸秆芯粉及农业废弃物秸秆芯粉为原料的吸附剂,具体为一种氧化石墨烯秸秆芯粉复合吸附剂及其制备方法和应用。本发明所述的吸附剂通过ZnCl2溶液活化秸秆芯粉,在ZnCl2溶液中实现秸秆芯粉和氧化石墨烯的自组装,然后冷冻干燥制得氧化石墨烯秸秆芯粉复合吸附剂。本发明氧化石墨烯秸秆芯粉复合吸附剂是一种新型三维结构复合材料;制备工艺简单;在较小吸附剂加入量下可实现对阳离子染料的高效去除。本发明首次采用石墨烯秸秆芯粉复合吸附剂作为吸附剂,对阳离子染料的吸附量高,吸附效果优异,便于分离,吸附后无二次污染,可以重复利用,是一种环保友好型吸附材料。

 1030
1030
 0
0
本发明涉及一种石墨烯包覆钛复合粉体材料及其制备方法,本发明采用的技术方案为:钛粉、异丙醇及3‑氨丙基三乙氧基硅烷偶联剂混合,然后放到磁力搅拌装置中一边加热,一边搅拌处理一段时间,使钛粉表面氨基化带正电荷;然后将钛粉加入到氧化石墨烯溶液中,放入磁力搅拌装置中进行搅拌,钛粉与氧化石墨烯发生静电吸附;最后将得到的氧化石墨烯/钛混合物进行真空抽滤、干燥,热还原、保温,得到还原氧化石墨烯包覆钛复合粉体材料;本发明方法反应条件简单,所需装置简单,操作方便,制备成本低,生产效率高,克服了以往复合材料制备中石墨烯团聚对复合材料性能的影响,易于进行大规模生产。
![基于[Ru(bpy)<sub>3</sub>]<sup>2+</sup>/Au@NiFe MOFs的免疫传感器的制备方法](https://img.china-mcc.com/tech_import_pic/28/138/6/16932.png)
本发明涉及一种基于新型纳米多孔材料Ru(bpy)32+/Au@NiFe MOFs的竞争型电致化学发光免疫传感器的制备方法及应用,属于电化学发光传感器领域,首次以纳米复合材料Ru(bpy)32+/Au@NiFe MOFs为电化学发光信号源,利用氨基功能化的介孔二氧化硅MSN优良的生物兼容性和大的比表面积增加抗体的固载量,根据不同浓度抗原引起的电化学发光信号强度的不同,实现对β‑淀粉样蛋白的检测。

本发明公开了一种基于磁电复合效应和磁记忆效应的多通道铁磁材料无损检测传感器及方法。传感器集成多个磁电检测元件,单个磁电检测元件设有层状磁电复合材料、压电信号输出导线、微扰线圈和压电层突出侧固化封装模块。微扰线圈与函数信号发生器相连,输出交流正弦电压信号,信号频率与磁电复合材料的谐振频率一致;压电信号输出导线与锁相放大器相连,测量压电层产生的电压信号。根据金属磁记忆技术,具有裂纹、气孔等缺陷的铁磁性材料表面存在磁场,磁电检测元件在有缺陷的被测金属表面,可以测得磁场信号,从而检测出工件近表面缺陷。本发明无需磁化被检测工件和磁粉、无需提供偏置磁场,具有体积小、灵敏度高、检测直观可靠等优点。

 802
802
 0
0
本发明公开了一种无贵金属掺杂、成本低、制备简单、高光电化学活性的双金属共掺杂二维纳米电极材料的制备方法。该方法在铁、锰共插层的二硫化钼纳米片上原位复合铁、锰共掺杂的二氧化钛纳米片材料,一锅法制备了铁、锰共掺杂二氧化钛纳米方块原位复合二硫化钼的二维纳米复合材料FeMn?TiO2/MoS2。所制备的FeMn?TiO2/MoS2可应用于太阳能光伏电池制备、光电化学传感器构建以及光催化水分解制氢、光催化降解有机污染物等领域。本发明属于新型纳米功能材料与绿色能源技术领域。

 1150
1150
 0
0
本发明公开了一种电化学氯霉素生物传感器的制备方法。属于新型纳米功能材料与生物传感器技术领域。本发明首先制备了一种新型二维纳米复合材料Mn?TiO2/g?C3N4,利用该材料的良好的生物相容性和大的比表面积,负载上氯霉素抗体,然后通过戊二醛的交联作用辣根过氧化物酶,在进行检测时,由于辣根过氧化物酶可以催化过氧化氢,产生电化学信号,再利用抗体与抗原的特异性定量结合对电子传输能力的影响,使得电流强度相应降低,最终制得了成本低、灵敏度高、特异性好、检测快速、制备简单的检测氯霉素的电化学生物传感器。

 1037
1037
 0
0
本发明公开了一种氯仿气体传感器的制备方法,具体是基于无机纳米复合材料构建的气体传感器的制备方法,属于新型纳米功能材料与环境安全监测技术领域。本发明首先采用一锅法制备了二硫化钼/铁钯合金纳米复合材料MoS2/FePd,将其涂覆于气敏元件上,进而制得了灵敏度高、响应快速的用于检测氯仿的气体传感器。

本发明涉及一种二甲苯气体传感器的制备方法,具体是基于双金属共掺杂二维纳米材料所构建的气敏传感器,可用于检测环境中二甲苯气体含量。属于新型纳米功能材料与环境监测技术领域。本发明首先制备了一种铁和锰双金属共掺杂的二氧化钛纳米片原位复合氮化碳二维纳米复合材料FeMn-TiO2/g-C3N4,利用该材料大的比表面积、介孔高气体吸附特性和电子传递受材料表面气体变化而影响敏感的诸多特性,实现了对二甲苯气体具有灵敏、快速响应的气敏传感器的构建。

 936
936
 0
0
本发明涉及一种超细碳化钒增强陶瓷刀具材料的制备方法,将TiB2-TiC共晶粉体、超细VC粉体、Al2O3粉和纳米Ni粉装入球磨机中,用Al2O3球球磨10-50小时后干燥并将混合粉末用200目筛过筛;将过筛后的混合粉末置于石墨容器中封闭,将石墨容器放入真空高温烧结炉内直接加热并缓慢加压,在30-50分钟内温度升至1650℃,压力升至30MPa,在1650℃温度、30MPa压力下保温30±10分钟,停止加热自然冷却。本发明利用超细VC与TiB2和TiC的良好相容性,在烧结过程中使VC能固溶进入TiC颗粒中形成固溶体,净化复合材料的晶界,阻止烧结过程中基体晶粒的异常长大,达到细化晶粒的目的,提高复合材料的综合力学性能。

 1088
1088
 0
0
本发明属于装甲防护材料技术领域,涉及人体防护材料技术,特别涉及防弹头盔用复合材料。本发明涉及的改性酚醛树脂半浸渗芳纶纤维预浸料,采用改性剂调整酚醛树脂的粘接强度和韧性,基体树脂部分浸渍芳纶纤维。本发明所涉及的改性酚醛树脂半浸渗芳纶纤维预浸料,由改性酚醛树脂与芳纶纤维织物组成,树脂浸渍部分芳纶纤维,浸渍率介于5%~20%之间,树脂的质量百分比介于8%~18%之间。该预浸料,胶含量均一性好、柔韧性好、使用方便,采用该预浸料制备的芳纶抗弹复合材料制品气孔率低、质量轻、结构强度高、防弹性能优异,适用于人体防护及装甲防护领域。
1147
1147
 0
0
本发明涉及MOF杀菌材料,属于功能性新材料领域。一种具有抗菌效果的MOF修饰材料,微观层面上铁离子与单宁酸形成络合物、络合物对MOF材料进行表面修饰,形成具有抗菌效果的MOF修饰材料。在本技术方案中,复合材料微观层面三价铁离子与TA形成络合网络,协助UiO‑66粒子在表面快速组装,且对MOF粒子具有“敏化”作用的同时保留了二者的光热作用,在模拟太阳光下产生ROS,实现光动力/光热力协同抗菌,赋予复合材料实用性的抗菌性质。

 942
942
 0
0
本发明涉及一种氰酸酯树脂潜伏性催化剂及其制备方法,属于催化氰酸酯树脂及其复合材料的制备技术领域;本发明采用微胶囊技术制备的氰酸酯潜伏性催化剂,当预浸料需要固化时,给予预浸料适当的压力或温度后,微胶囊破裂,固化剂进入基体,从而达到催化氰酸酯树脂固化的目的。除此之外本发明的潜伏性催化剂/氰酸酯树脂预浸料还具有更优的铺贴工艺性,利于氰酸酯树脂基复合材料成型。开阔了氰酸酯树脂基相关材料的应用范围,具有广阔应用前景。本发明的潜伏性催化剂以及氰酸酯树脂预浸料可以用于透波结构一体化部件用蒙皮的制备,满足天线雷达罩等部件对高透波率的需求,也可用作覆铜板基材,可在电子、航空、航天领域中得到广泛应用。

 830
830
 0
0
本发明提供一种氧化铝‑碳化钨钛‑石墨烯纳米片多相复相陶瓷材料的制备方法,本方法通过向Al2O3和(W,Ti)C中加入一定含量的高质量薄层石墨烯,以MgO和Y2O3粉末作为烧结助剂,经过超声分散、高能球磨和热压烧结制备了石墨烯强韧化的Al2O3基复相陶瓷材料。石墨烯纳米片在有效抑制Al2O3和(W,Ti)C颗粒增长的同时,引入了多种增韧机理,起到了细化晶粒,提高复合材料致密性的作用,进而显著提高了陶瓷复合材料的抗弯强度、硬度、断裂韧性和耐磨性。石墨烯为陶瓷刀具材料的强韧化提供了一种新的途径。步骤简单、操作方便、实用性强。

 801
801
 0
0
本发明公开了一种碳纤维的上浆方法及其应用,先在碳纤维表面涂覆碳量子点,然后再用上浆剂对碳纤维进行上浆处理。本发明利用碳量子点和上浆剂对碳纤维进行上浆处理,方法简单,通过碳量子点的引入及两步法的上浆方式,有效改善了碳纤维与基体树脂的界面相容性,有效提高了碳纤维复合材料的力学性能,有利于拓展碳纤维复合材料的应用范围,在碳纤维表面改性研究应用方面具有良好的发展前景。

本发明公开一种基于二氧化铈和纳米银双增强苝四羧酸发光的电化学发光传感器的构建方法。在本发明中,作为发光体的苝四羧酸PTCA直接负载在碳纳米管MWCNTs表面,形成PTCA@MWCNTs纳米复合材料。二氧化铈CeO2和纳米银AgNPs用作苝四羧酸‑过硫酸钾PTCA‑K2S2O8体系中新型共反应促进剂催化共反应剂K2S2O8产生更多的硫酸根自由基SO4•‑,极大增强了PTCA的发光强度。不同浓度的降钙素原PCT可结合不同量的二抗标记物金杂化的苝四羧酸‑碳纳米管Ab2‑Au‑PTCA@MWCNTs,从而引起传感器发光强度变化,实现对PCT的检测。本发明对PCT检测的线性范围为50 fg/mL‑100 ng/mL,检测限为16 fg/mL。

 1174
1174
 0
0
本发明公开了一种十二水硫酸铝钾/羟基化石墨烯复合储热材料及制备方法。本发明是将十二水硫酸铝钾、石墨烯的混合粉末球磨后分散在双氧水溶液中,水热处理后干燥,得到十二水硫酸铝钾/石墨烯复合材料。所得复合材料可以有效减小十二水硫酸铝钾的过冷度,并提高材料导热性能。本发明制备方法反应条件可控,设备要求简单,易于实现批量生产,有利于环境保护。

 1176
1176
 0
0
本发明涉及一种锂离子电池正极材料Ni(OH)2@Au及其制备方法、应用,包括:将纳米材料Ni(OH)2超声分散于含有活化剂的溶液中,使纳米Ni(OH)2均匀分散,以保证整个纳米Ni(OH)2表面都能充分活化,超声时间以1‑100min为宜;再将活化后的Ni(OH)2分散HAuCl4溶液中,在搅拌下陈化1‑24h,以保证纳米Ni(OH)2对Au离子及化合物的饱和陈化,将产物用去离子水漂洗数次,干燥,即得Ni(OH)2@Au纳米半导体复合材料。Ni(OH)2是锂离子电池中常用的正极材料,通过外层修饰Au得到的新型纳米半导体材料具有更高的导电性和比表面积,可增大电容容量,增强循环稳定性。本发明制备的纳米半导体复合材料Ni(OH)2@Au提高了电极循环稳定性,有利于改善电极的循环寿命。

 826
826
 0
0
本发明涉及一种镍包覆六方氮化硼复合粉体的制备方法,该方法包括:将h‑BN粉体加入敏化液中,超声条件下进行敏化;将敏化后的h‑BN粉体加入活化液中,超声条件下活化处理,分离、干燥得到活化的h‑BN粉体;将活化后的h‑BN粉体加入pH值为11‑12的化学镀液中,恒温水浴施镀;清洗、干燥后得到h‑BN@Ni复合粉体。本发明制备的h‑BN@Ni复合粉体包覆效果好,分散性好,添加应用到金属基和陶瓷基固体自润滑复合材料中,可使固体自润滑复合材料的抗弯强度、硬度和断裂韧性同时得以提高。本发明方法的设备简单,操作简便,安全性高,成本低。

 793
793
 0
0
本发明公开了一种PVC‑铝矾土路沿石及其制备方法,该路沿石由46%PVC磨粉料、42%铝矾土、6%抗冲改性剂、3%复合稳定剂、0.7%内润滑剂、0.7%外润滑剂和1.6%抗老化剂组成;本发明以废旧PVC塑料与铝矾土为原料,通过挤塑技术成型的一种新型复合材料生产和应用技术体系,是废物循环利用,减少废弃回收料对环境污染的最佳实用技术,是当前废物再利用生产建材产品的有效途径,也是取代当石材、大理石、花岗石的新型替代品。本技术开发的复合材料产品具有耐酸碱、耐水、抗老化、防火性能好等优势,在倡导绿色环保的今天,开发研究出PVC/铝矾土路沿石具有深远的意义。
中冶有色为您提供最新的山东济南有色金属复合材料技术理论与应用信息,涵盖发明专利、权利要求、说明书、技术领域、背景技术、实用新型内容及具体实施方式等有色技术内容。打造最具专业性的有色金属技术理论与应用平台!
 2025年10月23日 ~ 25日
2025年10月23日 ~ 25日  2025年10月31日 ~ 11月02日
2025年10月31日 ~ 11月02日  2025年11月07日 ~ 09日
2025年11月07日 ~ 09日  2025年11月14日 ~ 16日
2025年11月14日 ~ 16日  2025年11月14日 ~ 16日
2025年11月14日 ~ 16日 
